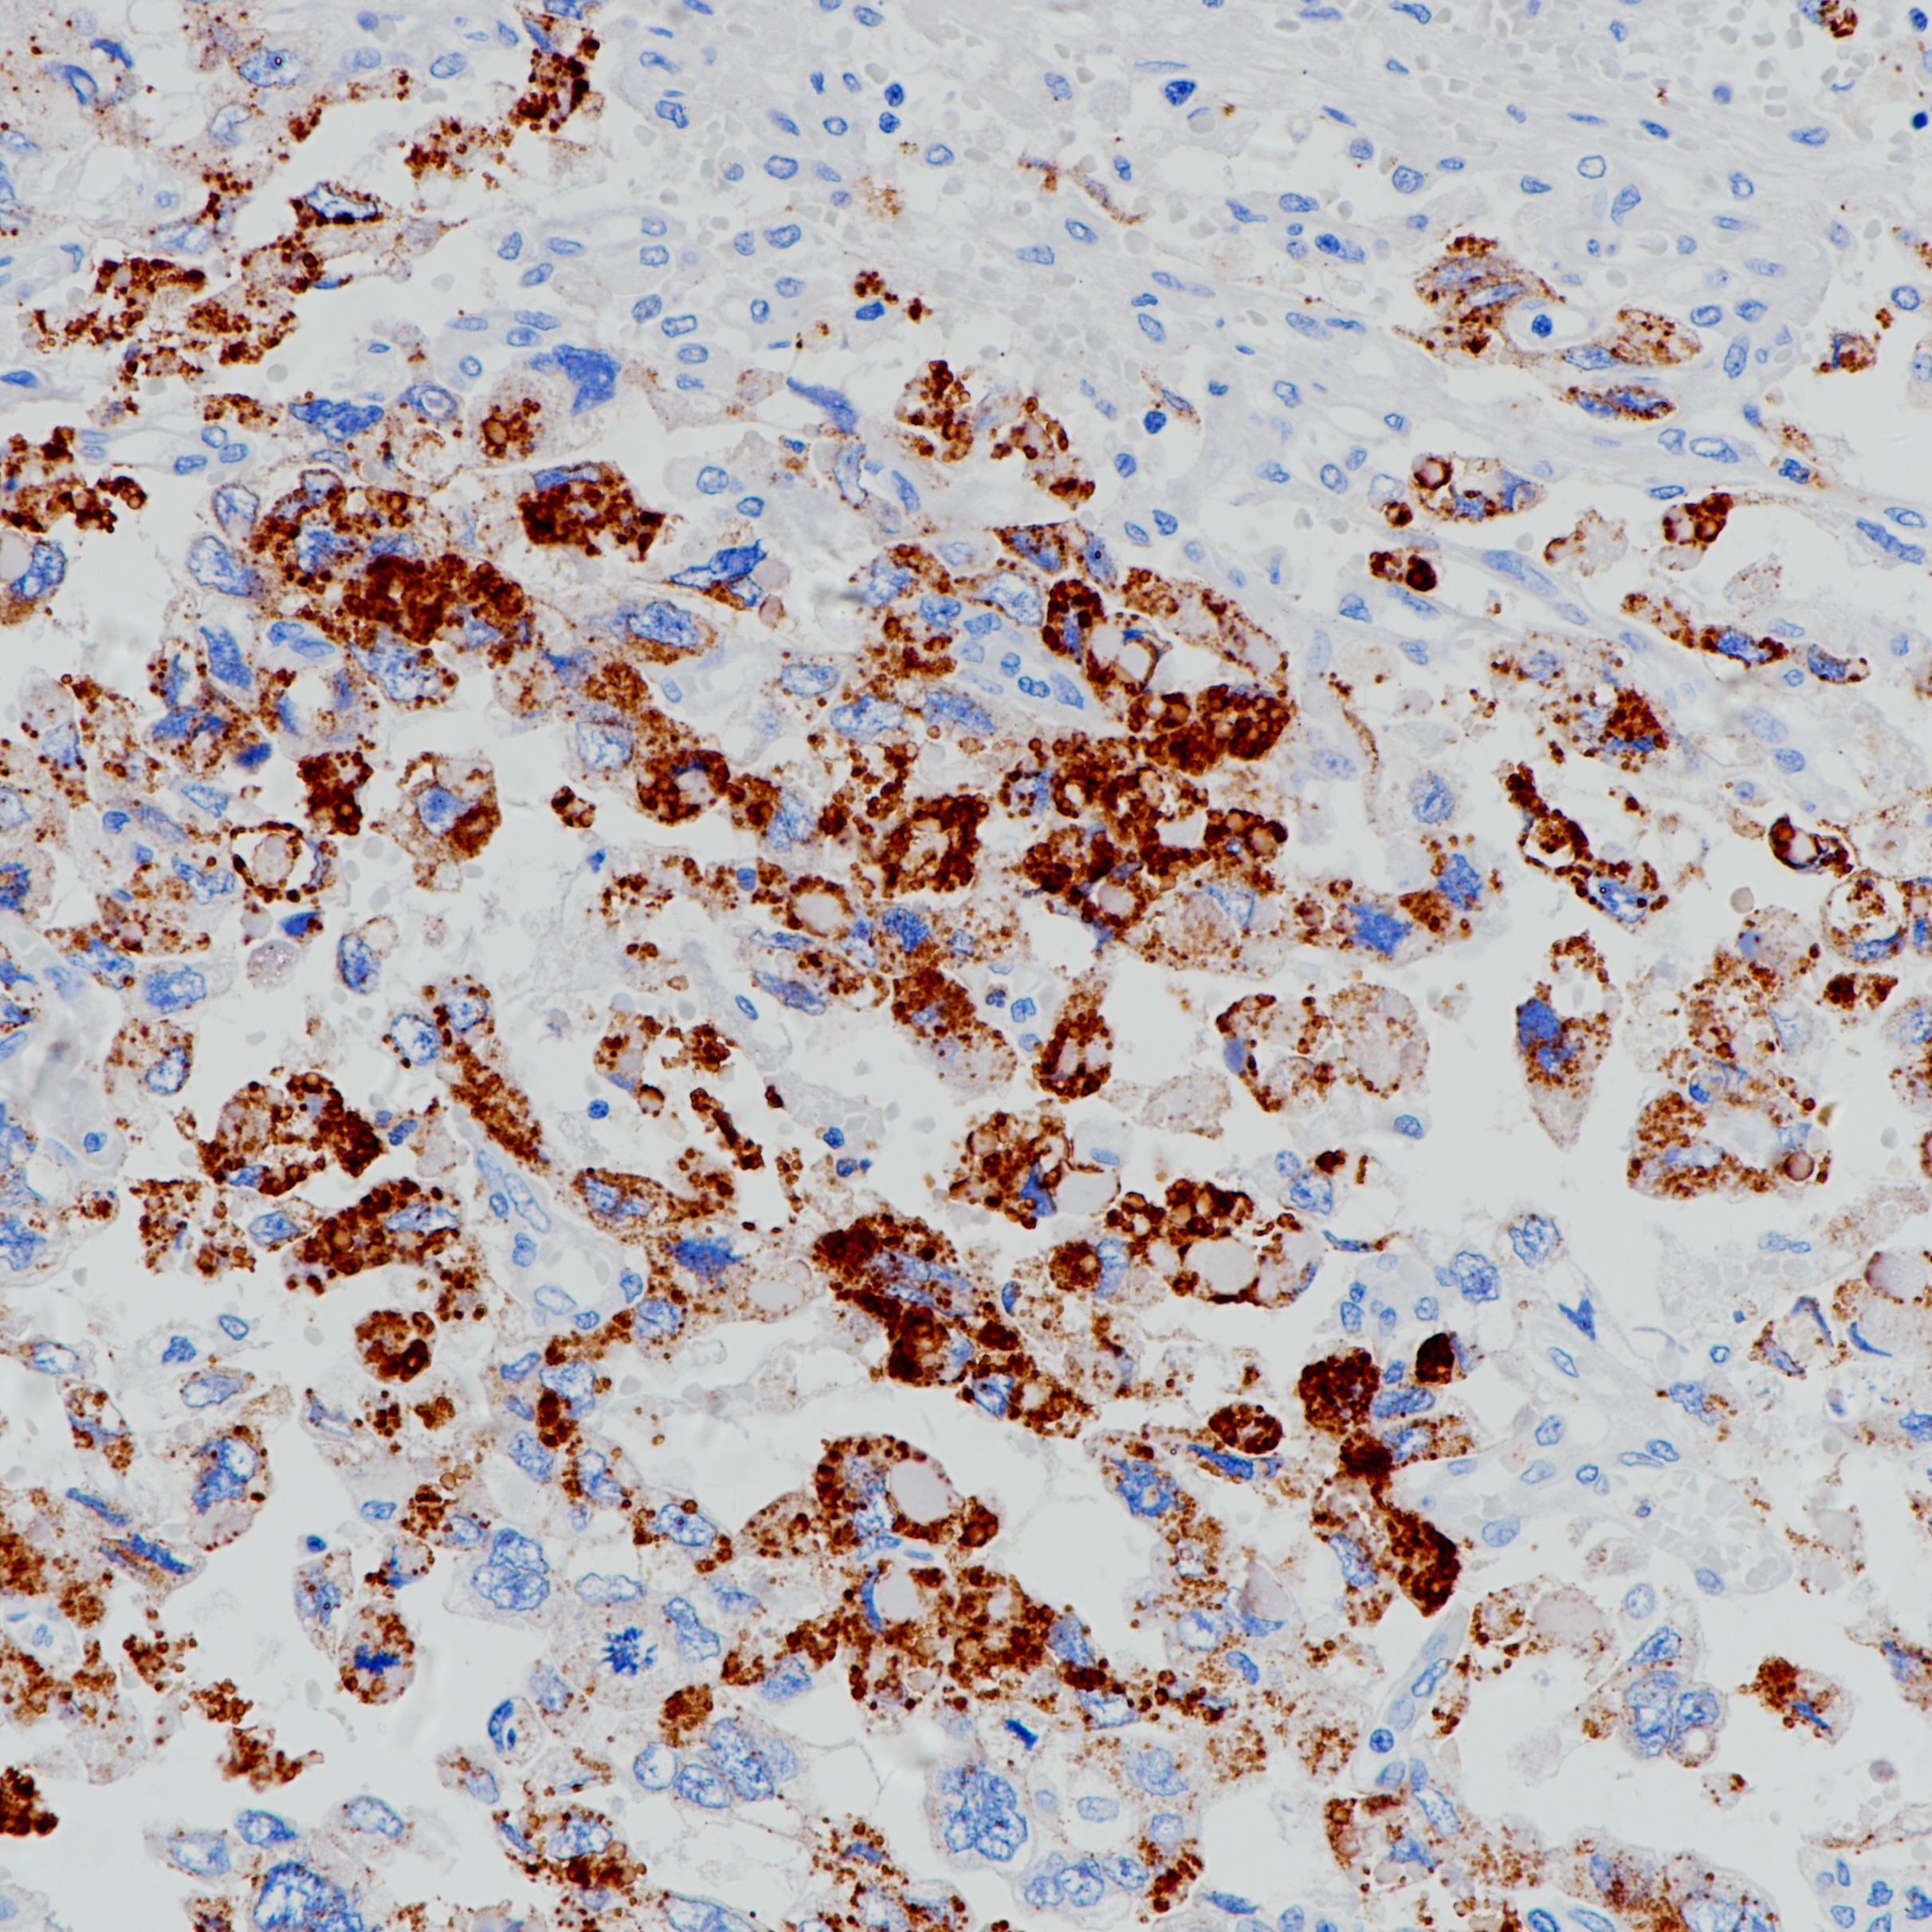
胚胎性癌 GLP3（BP6228）染色

1. Capurro M, et al. Gastroenterology. 2003 Jul;125(1):89-97.
2. Zhou F,Shang W, Yu X, Tian J. Glypican-3: A promising biomarker for hepatocellular carcinoma diagnosis and treatment. Med Res Rev. 2018 Mar;38(2):741-767. doi: 10.1002/med.21455. Epub 2017 Jun 16.